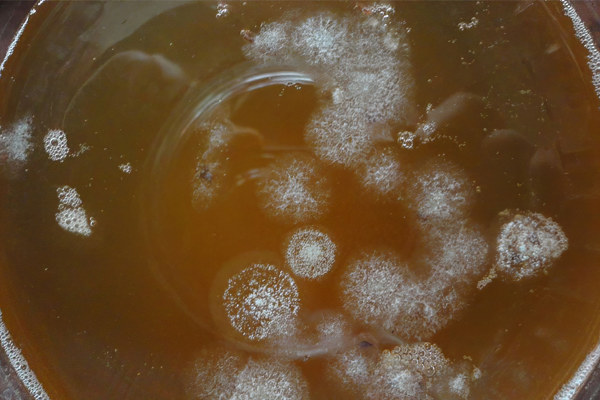
Белые пятна на чайном грибе Белые пятна на чайном грибе

Полезные свойства чайного гриба
Полезные качества чайного гриба известны на Востоке на протяжении веков. Японские гейши использовали его для поддержания стройной фигуры, удаления бородавок и пигментных пятен, а также полоскали волосы раствором после мытья. В Индонезии этот продукт служил эффективным противоядием при различных отравлениях.
Вот некоторые эффекты чайного гриба, о которых сообщают любители чая и российские исследователи:
- Оказывает детоксикационное действие.
- Снижает уровень холестерина.
- Способствует регенерации стенок сосудов, что помогает уменьшить симптомы атеросклероза.
- Уменьшает артериальное давление.
- Обладает противовоспалительными свойствами.
- Улучшает функции печени.
- Нормализует работу кишечника, восстанавливает микрофлору и помогает при геморрое.
- Снижает уровень ожирения и регулирует аппетит.
- Помогает при инфекциях мочевого пузыря и уменьшает образование камней в почках.
- Стимулирует работу всех желез внутренней секреции.
- Защищает от диабета.
- Повышает устойчивость организма к онкологическим заболеваниям.
- Обладает антибиотическими свойствами против бактерий, вирусов и грибков.
- Укрепляет иммунную систему и способствует выработке интерферона.
- Снижает нарушения менструального цикла и облегчает приливы в период менопаузы.
- Улучшает состояние волос, кожи и ногтей.
- Уменьшает тягу к алкоголю.
- Снижает уровень стресса, нервные расстройства и помогает при бессоннице.
- Облегчает головные боли.
- Ускоряет общий обмен веществ.
Чайный гриб, или комбуча, вызывает интерес у врачей благодаря своим потенциальным полезным свойствам. Исследования показывают, что он может способствовать улучшению пищеварения, укреплению иммунной системы и даже снижению уровня холестерина. Однако, несмотря на положительные аспекты, медики предупреждают о возможных рисках. Неправильное приготовление или хранение гриба может привести к развитию патогенных микроорганизмов, что может вызвать отравление.
Выращивание чайного гриба не требует особых навыков. Для этого необходимо создать подходящие условия: использовать чистую посуду, качественный чай и сахар. Уход за грибом включает регулярное кормление сахаром и контроль за температурой. Врачи советуют следить за состоянием гриба и не употреблять его в больших количествах, чтобы избежать нежелательных реакций организма. Важно помнить, что перед началом употребления комбучи стоит проконсультироваться с врачом, особенно при наличии хронических заболеваний.

Состав чайного гриба
Польза чайного гриба объясняется множеством биологически активных компонентов в его составе. В него входят органические и угольные кислоты, такие как уксусная, глюконовая, глюкуроновая, лимонная, L-молочная, яблочная, винная, малоновая, щавелевая, янтарная, пировиноградная и усниновая. Также присутствуют полисахариды, белки, сахара, эфирные масла, витамины группы B1, B2, B6, B12 и C. Чайный гриб содержит 14 аминокислот, биогенные амины, пурины, пигменты, липиды, гидролитические ферменты, этанол, антибиотически активные вещества, углекислый газ, фенол и полифенолы чая. Кроме того, в нем есть минералы, такие как марганец, железо, никель, медь, цинк, свинец, кобальт и хром, а также анионы, DSL и менее известные продукты дрожжевых и бактериальных метаболитов.
| Витамины на 100 мл | Количество | % РДН |
| Витамин B1 (тиамин) | 74 мг | 6160% |
| Витамин B2 (рибофлавин) | 83 мг | 6380% |
| Витамин B6 (пиридоксин) | 52 мг | 4070% |
| Витамин B12 (цианокобаламин) | 84 мкг | 3500% |
| Витамин С (аскорбиновая кислота) | 151 мг | 167% |
Источник: Содержание минералов и водорастворимых витаминов в напитке комбуча
В чайном грибе также содержатся бактерии с антибиотическими свойствами, способные уничтожать или замедлять рост различных патогенных микроорганизмов. Наиболее распространенные прокариоты в этой культуре относятся к родам Acetobacter и Gluconobacter.
Содержание этанола в напитке со временем возрастает, достигая максимального уровня 0,5 г на 100 мл. Пик концентрации спирта наблюдается на 6-й день, после чего оно начинает снижаться. Уровень белка также увеличивается в диапазоне от 0,01 г до 0,3 г на 100 мл в течение 12 дней ферментации.
| Аспект | Польза | Вред/Меры предосторожности |
|---|---|---|
| Состав и свойства | Богат пробиотиками, витаминами (группы B, C), органическими кислотами. Улучшает пищеварение, укрепляет иммунитет, обладает антиоксидантными свойствами. Может помочь при проблемах с ЖКТ (в умеренных количествах). | Может содержать небольшое количество алкоголя (до 1%). Может вызвать аллергические реакции. Не рекомендуется при заболеваниях почек, печени, сахарном диабете (без консультации врача). Избыточное потребление может привести к расстройствам желудка. |
| Выращивание | Простой процесс, требует минимальных затрат. Можно использовать различные емкости (стеклянные банки). Быстрый рост культуры. | Требует соблюдения чистоты, чтобы избежать заражения плесенью или бактериями. Необходимо следить за температурой и освещением. Может потребоваться периодическая чистка и пересадка. |
| Уход | Регулярное подслащивание (сахарный песок, лучше не использовать рафинированный). Замена заварки (чай черный или зеленый). Промывание чайного гриба чистой водой. Хранение в прохладном месте, избегая прямых солнечных лучей. | Переизбыток сахара может привести к образованию плесени. Недостаток сахара замедлит рост. Застой жидкости может привести к закисанию. Необходимо следить за состоянием гриба (цвет, запах, консистенция). |
| Употребление | Утоляет жажду, освежает. Может быть использован в качестве основы для различных напитков (с добавлением фруктов, ягод, трав). | Не следует употреблять напиток, если он имеет неприятный запах или вкус. Не рекомендуется употреблять слишком много напитка за один раз. Хранить готовый напиток в холодильнике не более 3-5 дней. |
Чайный гриб – это антимикробный напиток
Антимикробная активность чая из чайного гриба обусловлена органическими кислотами, в первую очередь уксусной, а также белками и катехинами. Установлено, что уксусная кислота и катехины подавляют множество грамположительных и грамотрицательных микроорганизмов.
Например, этот напиток эффективен против таких микроорганизмов, как Entamoeba клоаки, синегнойная палочка, Bacillus cereus, кишечная палочка, Aeromonas hydrophila, сальмонелла Typhimurium, сальмонеллы Enteritidis, шигеллы, стафилококк эпидермальный, Leuconostoc моноцитогенных, Yersinia, золотистый стафилококк, Campylobacter jejuni, Helicobacter pylori и Candida albicans. Однако он не влияет на Candida. Чайный гриб, заваренный на зелёном чае, обладает наивысшим антимикробным потенциалом.
Чайный гриб, или комбуча, привлекает внимание как сторонников, так и противников. Многие хвалят его за полезные свойства: он богат пробиотиками, витаминами и антиоксидантами, что способствует улучшению пищеварения и укреплению иммунной системы. Однако некоторые специалисты предупреждают о возможных рисках, таких как аллергические реакции или неправильное приготовление, что может привести к отравлению.
Вырастить чайный гриб несложно. Для этого потребуется сладкий черный или зеленый чай и стартовая культура гриба. Процесс ферментации занимает от 7 до 14 дней, в зависимости от желаемой крепости напитка. Уход за грибом включает регулярное кормление сладким чаем и поддержание чистоты. Важно следить за температурой и избегать прямых солнечных лучей. Правильный уход обеспечит не только вкусный, но и полезный напиток, который станет отличным дополнением к вашему рациону.

Чайный гриб – это источник антиоксидантов
Антиоксидантные свойства чайного гриба связаны с его множеством положительных эффектов, включая профилактику рака, укрепление иммунной системы и снижение воспалительных процессов, таких как артрит. Эти характеристики обусловлены содержанием полифенолов и аскорбиновой кислоты. Уровень активности антиоксидантов зависит от продолжительности ферментации.
Чайный гриб – это гепатопротектор
Чайный гриб снижает риск гепатотоксичности, вызванной загрязняющими веществами, такими как парацетамол, тетрахлорид углерода, афлатоксин B1, хлорид кадмия и ацетаминофен. Он эффективно уменьшает физиологические изменения, возникающие из-за воздействия токсичных веществ на печень.

Чайный гриб – это средство против рака
Химиопрофилактика с использованием диетических фитохимических веществ рассматривается как эффективный метод борьбы с различными формами рака, при этом с меньшим количеством побочных эффектов. На протяжении многих лет сторонники чайного гриба уверенно утверждают о его противораковых свойствах. В 1951 году были проведены исследования, инициированные Центральным онкологическим исследовательским отделом и Российской академией наук в Москве.
Исследования показали, что чайный гриб оказывает цитотоксическое воздействие на карциному почек, карциному легких, остеосаркому и рак простаты, снижая подвижность, инвазию и выживаемость раковых клеток.
Вред чайного гриба
В ходе научных исследований не было выявлено негативного влияния чайного гриба на человеческий организм. Его использование для наружного применения и в качестве протирания абсолютно безопасно. Напиток из чайного гриба могут пить как взрослые, так и дети. Однако важно помнить, что безопасность обеспечивается только при соблюдении гигиенических норм и правильном приготовлении настоя из натурального чая с использованием свежей воды.
Несмотря на множество полезных свойств, чайный гриб следует применять с осторожностью. Он противопоказан людям с:
- Повышенной кислотностью желудка;
- Язвой желудка;
- Подагрой;
- Сахарным диабетом (напиток не должен быть сладким);
- Грибковыми инфекциями;
- Индивидуальной непереносимостью компонентов продукта.
Хотя количество полезных веществ увеличивается с каждым днем, длительная ферментация не рекомендуется из-за накопления органических кислот, которые могут достигать опасных уровней.
Если вы заметили плесень или другие проблемы с напитком, лучше его выбросить. Употребление такого продукта может привести к отравлению, нарушению работы печени и острому почечному недостатку.
В целом, настой из чайного гриба не представляет опасности для здоровья. Управление по санитарному надзору за качеством пищевых продуктов и медикаментов США, а также Kappa Laboratories из Майами, штат Флорида, провели микробиологические и биохимические исследования и подтвердили безопасность чайного гриба для употребления.
Тем не менее, рекомендуется воздержаться от его употребления тем, кто управляет автомобилем, так как в чайном грибе содержится небольшое количество алкоголя.
Также зафиксированы случаи отравления свинцом, когда чайный гриб хранился в керамической или глиняной посуде. Поэтому обязательно используйте только стеклянные емкости!
Применение чайного гриба
Народная медицина различных стран давно использует целебные свойства чайного гриба. Его применяют для лечения заболеваний кишечника, почек, мочевого пузыря, печени и нервной системы, а также для облегчения головной боли. Этот гриб обладает противовоспалительными и антибиотическими свойствами, нормализует работу желудочно-кишечного тракта, снижает уровень холестерина и артериальное давление. Он зарекомендовал себя как эффективное профилактическое средство против полиартрита, ревмокардита и атеросклероза.
Настои из чайного гриба часто используют при хроническом насморке, ангине и тонзиллите. Многие специалисты отмечают, что даже при дизентерии этот напиток может оказать более качественное воздействие, чем некоторые аптечные лекарства. Употребление раствора чайного гриба помогает справиться с бессонницей и уменьшить боли в области сердца. Это природное средство обладает успокаивающим эффектом и положительно сказывается на общем состоянии здоровья пациентов.
Где взять уже готовый чайный гриб?
Существует несколько способов получить чайный гриб. Чаще всего от материнского гриба отделяют дочерний слой и помещают его в подготовленную банку. Также можно купить готовый продукт в магазине или вырастить его самостоятельно дома.
1 Отделить слой от материнского гриба
Гриб развивается быстро, поэтому его часто приходится делить. Если у вас нет знакомого, который занимается выращиванием комбучи, можно обратиться к другим. Многие пользователи щедро предлагают чайный гриб за символическую плату или даже бесплатно.
Перед покупкой комбучи внимательно осмотрите гриб. Здоровый чайный гриб должен иметь плотную и целостную структуру, а также однородный цвет, который обычно варьируется от молочного до коричневого.
Если гриб отделился от материнского, сохраните немного жидкости, в которой он рос. Стакан «родной» жидкости поможет первой порции комбучи быстрее адаптироваться и станет постоянной закваской.
Правильное питание чайного гриба ускоряет процессы ферментации чая. Через семь дней вы сможете насладиться первой порцией напитка.
2 Купить набор для выращивания чайного гриба
На нашем сайте можно приобрести комплект, который включает материнский гриб. В него также входит немного питательного раствора, упакованного в вакуум. Этот раствор добавляется в новую ёмкость с комбучей, что способствует быстрой адаптации гриба в новой среде. Кроме того, доступны наборы с уже готовым грибом.
Вы можете выбрать комплект, который включает чайный гриб и лимонадник (ёмкость с краником). В некоторых наборах также есть бутылки для разлива и хранения напитка, а также рН-полоски для измерения кислотности. По специальной шкале можно определить степень готовности продукта. Высокое значение рН указывает на то, что процесс ферментации ещё не завершён. Если рН-полосок нет, о готовности напитка можно судить по его вкусу: готовый продукт будет сладким и пузырящимся.
Чтобы вырастить покупной гриб, потребуется около двух недель при соблюдении правил кормления. Материнское тело комбучи помещается в ёмкость с закваской и сладким чаем, где оно опускается на дно. Рост гриба можно наблюдать уже через несколько кормлений, и постепенно появляется характерный вкус и газировка.
3 Выращивание из домашнего настоя
Если у вас есть возможность получить настой чайного гриба (без медузомицета), вы сможете легко его вырастить. Однако важно использовать именно домашний напиток, а не тот, что продается в магазинах. Дело в том, что перед продажей чайный гриб подвергается пастеризации, что делает его неспособным к дальнейшему росту.
Исследования показывают, что домашний гриб содержит высокую концентрацию дрожжей и бактерий. В банку нужно налить 1-2 стакана настоя и поместить её в темное место. Оптимальная температура для этого процесса составляет 22-26°C. Появление тонкой пленки на поверхности указывает на начало развития новой культуры. Регулярные подкормки способствуют росту чайного гриба и активируют ферментацию напитка.
Как вырастить чайный гриб?
Обратите внимание. При приготовлении чайного гриба важно соблюдать чистоту. Рекомендуется предварительно стерилизовать ёмкость для его выращивания. Все инструменты, такие как ложки, воронки и ситечки, следует ошпарить кипятком или протереть уксусом. Не забудьте тщательно вымыть руки!
Делаем напиток с готовым чайным грибом
Самый простой способ — приобрести или взять в аренду готовый медузомицет, то есть отросток гриба у людей, занимающихся его разведением. Мы уже упоминали три способа его получения. Если вы хотите вырастить медузомицет самостоятельно с нуля, следуйте приведенной ниже инструкции.
Приготовление комбучи:
- В отдельной емкости заварите чай (без добавок, крупнолистовой) — 1 столовую ложку на стакан кипятка. Дайте настояться 10 минут.
- В другой посуде растворите в кипятке 4-6 столовых ложек сахара. Количество сахара зависит от того, хотите ли вы, чтобы напиток был более кислым или сладким. Можно добавить и больше, но помните: чем больше сахара, тем быстрее гриб будет скисать. Сахар нужно растворить заранее и тщательно перемешать, так как крупные кристаллы могут повредить гриб.
- В трехлитровую банку влейте растворенный сахар. Затем, используя сито с марлей, влейте приготовленный чай. Важно, чтобы чайные частицы не попали в раствор.
- Если вы приобрели чайный гриб в магазине или делаете его впервые, добавьте 1-2 столовые ложки яблочного уксуса. Это поможет защитить гриб от плесени. Если вы уже не в первый раз готовите комбучу, уксус добавлять не нужно.
- Долейте кипяченую воду до объема 2 литра, оставив немного места в верхней части банки, чтобы комбуча не образовывала конус.
- Измерьте температуру раствора — она не должна превышать 40 градусов! В противном случае гриб может погибнуть. Лучше дождаться, пока раствор остынет до комнатной температуры.
- В остывший раствор аккуратно поместите готовый гриб светлой стороной вверх, темной вниз (можете подправить его стерильным пинцетом).
- Накройте банку чистой марлей, закрепив ее резинкой. Это позволит раствору дышать и защитит его от пыли. Закрывать крышкой нельзя, так как медузомицет нуждается в кислороде. Оставляя банку открытой, вы рискуете, что внутрь попадут насекомые и испортят напиток.
- В начале медузомицет может не всплывать на поверхность. Не переживайте — уже через несколько дней он поднимется со дна банки.
- Напиток будет готов к употреблению через 3–7 дней. О готовности свидетельствует появление пузырьков на поверхности.
[Видео] Инструкция по правильному приготовлению комбучи (при наличии чайного гриба) + различные вкусы:
Если готового гриба нет, его можно приготовить самостоятельно, но для этого потребуется запастись терпением.
Классический рецепт, как вырастить чайный гриб с нуля
Способ приготовления:
-
Возьмите банку объемом 0,5 литра. Когда ваш мезудомицет вырастет, его можно будет переместить в трехлитровую емкость, но на начальном этапе лучше использовать небольшую. Тщательно промойте банку теплой водой с добавлением соды и проведите стерилизацию.
-
Наполните банку 0,5 литра кипяченой воды. Важно, чтобы вода остыла, так как горячая вода уничтожит все бактерии, и гриб не сможет развиваться.
-
Всыпьте 2 столовые ложки сахара с горкой и тщательно перемешайте до полного растворения.
-
Добавьте две чайные ложки крупнолистового чая (черного или зеленого) без добавок. Листья чая должны оставаться в растворе на весь период роста, поэтому процеживать его не нужно.
-
Чтобы защитить гриб от плесени, добавьте 2 столовые ложки натурального яблочного уксуса в заварку. Можно использовать и 9% столовый уксус, но предпочтительнее яблочный. Уксус добавляется только в начале процесса, а затем гриб будет самостоятельно его вырабатывать.
-
Накройте горлышко банки марлей, закрепив ее резинкой.
-
Поместите банку в теплое темное место. Оптимальная температура составляет +25℃. Если температура будет ниже, это не критично, но процесс займет больше времени. Не ставьте банку на окно, так как прямые солнечные лучи негативно влияют на бактерии.
В конце первой недели на поверхности появятся белые пятна – это не плесень, а формирующийся гриб. Эти пятна представляют собой колонии микробов, образующиеся в результате симбиоза уксуснокислых бактерий и дрожжей.
-
Обычно первая тонкая пленка толщиной 1 мм появляется через 2-3 недели. В этот период не трогайте гриб и старайтесь не перемещать банку, чтобы не повредить зарождающийся гриб.
-
Дождитесь, пока толщина пленки не достигнет 4-5 мм. Это займет еще примерно месяц. Когда гриб вырастет до нужного размера, его можно пересадить в трехлитровую банку. Важно пересаживать его вместе со старым раствором!
-
Затем повторите все предыдущие шаги (приготовление напитка с готовым чайным грибом) ↑.
[Видео] Подробная инструкция – чайный гриб с нуля, без плесени! Проверенный рецепт!
Как кормить чайный гриб (менять настой на новый)?
Каждая хозяйка сама решает, сколько чая, сахара и закваски использовать для кормления комбучи. Скорость брожения и ферментации напитка зависит от времени года и температуры окружающей среды. Обычно нужное количество ингредиентов определяется по вкусу напитка.
Если вы ощущаете ярко выраженную сладость, это может означать, что дрожжи не успели переработать весь сахар. Однако гриб стремится максимально переработать сахар, что приводит к увеличению выделения кислот.
Кормить гриб довольно просто, если следовать нескольким основным правилам:
- Заварите 4 чайные ложки листового чая и дайте настояться около 10 минут. Можно использовать фильтр-пакеты для удобства.
- На литр воды добавьте 60-80 г сахара (4-5 столовых ложек) и тщательно размешайте, чтобы не осталось крупинок. Если крупинки попадут на нежную поверхность грибка, это может его повредить.
- Перелейте свежезаваренный чай в подготовленную емкость для грибка, добавьте сахарный раствор и доведите до нужного объема прохладной кипяченой водой. Не используйте воду из-под крана, так как она может быть слишком жесткой.
- Остудите жидкость до комнатной температуры. Температура настоя не должна превышать 30°C.
- После этого добавьте закваску (примерно 150-200 мл предыдущей комбучи), погрузите чайный гриб, накройте салфеткой и закрепите резинкой. Поместите банку в хорошо проветриваемое место, защищенное от прямых солнечных лучей.
- Первую пробу напитка можно провести через 3-7 дней. Если вкус слишком кислый или недостаточно газированный, возможно, потребуется скорректировать дозировку сахара или закваски.
Как часто можно сливать настой, и нужно ли мыть гриб?
В летний период настой чайного гриба следует сливать каждые 2–4 дня, а зимой — раз в 4–6 дней. Гриб необходимо промывать чистой прохладной водой примерно раз в три недели.
Если гриб останется в растворе слишком долго, его верхняя пленка может потемнеть. При недостаточной подкормке или полном прекращении питания этот организм может заболеть и погибнуть, опускаясь на дно. В таком случае употребление его настоя строго запрещено.
Как промывать чайный гриб?
Существует мнение, что коричневые нити дрожжей, обвивающие нижнюю часть грибного тела, не вызывают симпатии у российских пользователей. Несмотря на их непривлекательный вид, эти нити играют важную роль в ферментации.
Некоторые источники настоятельно советуют не мыть гриб. При промывании удаляются необходимые дрожжи и бактерии, что может ослабить комбучу.
Рекомендуется раз в месяц избавляться от отделившихся нитей. Для этого гриб следует поместить в миску с водой комнатной температуры и аккуратно удалить нити.
Какой стороной класть чайный гриб в банку?
Верхняя часть гриба имеет светлый цвет и гладкую, плотную текстуру. Нижняя сторона, наоборот, темная, рыхлая и волокнистая. Именно в этой нижней части находятся колонии полезных микроорганизмов, которые обогащают заварку витаминами. Чтобы сохранить их симбиотические отношения, гриб следует укладывать так, чтобы темная и рыхлая сторона была направлена вниз, а светлая и гладкая поверхность оставалась на виду.
Важные нюансы хранения
Основные требования для успешного выращивания чайного гриба заключаются в защите от солнечного света и обеспечении стабильного доступа воздуха. Для длительного хранения комбучи и качественной ферментации важно учесть несколько ключевых аспектов.
Ёмкость
Рекомендуется выбирать стеклянную банку с широким горлышком. Трёхлитровая банка не подходит, так как её узкое горлышко усложняет извлечение гриба и может привести к его повреждению. Микроскопические травмы на поверхности создают благоприятные условия для развития нежелательной флоры. В магазинах можно найти лимонадники — большие ёмкости с краном, удобные для дегустации и разлива напитка по бутылкам.
Ещё более практичным вариантом является использование диспенсера для напитков.
Чем накрывать банку?
Ёмкость с комбучей нужно накрыть хлопковой салфеткой или сложенной в несколько слоёв марлей, закрепив резинкой. Такая крышка обеспечит хорошую вентиляцию, позволяя дрожжам и бактериям получать необходимый воздух. Салфетка также защитит гриб от насекомых, привлечённых сладким ароматом.
Не закрывайте банку крышкой или фольгой. Это может привести к гибели комбучи, так как плотные материалы не пропускают кислород, необходимый для роста дрожжей и бактерий.
Место хранения, температура
Для успешного развития чайного гриба оптимальная температура составляет 22-26°C. Ёмкость нужно защищать от прямых солнечных лучей, чтобы избежать образования микроскопических водорослей. Ультрафиолетовое излучение может способствовать росту спор в воде.
Не стоит размещать ёмкость с комбучей в шкафу. Недостаток воздуха увеличивает риск появления плесени на поверхности. Для хранения подойдут не только кухонные полки, но и свободные места в коридоре.
Влияние окружающей температуры на качество напитка
На активность, рост и вкус чайного гриба в первую очередь влияет температура. При пониженных температурах замедляется ферментативная активность, что негативно сказывается на обменных процессах дрожжей и бактерий. При температуре 20-23°C снижается способность дрожжей расщеплять сахар, что приводит к уменьшению выработки алкоголя и снижению синтеза уксусной кислоты. В результате напиток становится более сладким и мягким на вкус, а уксусные нотки едва заметны. Таким образом, процесс приготовления занимает больше времени — около месяца.
Снижение температуры до 18°C и ниже считается критическим для комбучи. В таких условиях в питательной среде начинают активно размножаться патогенные микроорганизмы, плесневые грибы и водоросли.
Слишком высокая температура приводит к прокисанию чайного гриба. Дрожжи начинают действовать активнее, чем бактерии, что снижает выработку полезных органических кислот и витаминов. Это создает дисбаланс в составе напитка, придавая ему выраженный кислый вкус. Чем больше дрожжей в комбуче, тем выше уровень газа и меньше пробиотических бактерий.
Температура не должна превышать 30°C, иначе комбуча может погибнуть. Чтобы минимизировать риски, рекомендуется использовать термометр для измерения температуры чая. Если специального градусника нет, можно опустить в жидкость мизинец — она должна быть приятно теплой.
Как правильно разделить чайный гриб для размножения?
Если у ваших знакомых есть чайный гриб, вы можете попросить у них небольшой кусочек. При правильном уходе из него уже через несколько недель вырастет крепкий и здоровый гриб. Он быстро растет, но слишком крупный гриб теряет полезные свойства, поэтому его следует делить и распределять по нескольким банкам. Важно действовать аккуратно, чтобы не повредить его.
Делить гриб можно, когда его толщина достигнет 4 см. Не стоит слишком часто вмешиваться в его жизнь, иначе новые слои не успеют насытиться витаминами и минералами.
Инструкция по разделению чайного гриба:
- Тщательно вымойте руки.
- Слейте всю жидкость из банки, аккуратно извлеките гриб и разместите его на тарелке.
- Найдите участки, где слои начинают отделяться друг от друга.
- Осторожно отделите их пальцами.
- Промойте отделённый слой чистой водой.
- Поместите разделённые слои в новый раствор сладкого чая.
Основа гриба, которая дала потомство, начнёт обогащать напиток питательными веществами сразу же. Чтобы этот процесс запустился в новой банке, потребуется от 14 до 20 дней. Резать чайный гриб нельзя, так как использование острых металлических предметов может привести к его гибели. Слои следует разделять только пальцами в местах, где они расхождены.
Важно помнить, что верхнюю часть зрелого гриба отделить довольно просто. Если при попытке снять слой он не поддаётся, значит, время для этого ещё не пришло.
Иногда гриб сам отделяет дочернюю пластинку. В этом случае основа опускается на дно банки, а через несколько дней или даже часов на поверхности появляется тонкая плёнка. Её нужно аккуратно извлечь и поместить в новую банку. При должном уходе из этой «малышки» вырастет новый здоровый гриб.
Болезни чайного гриба и пути их решения
Чайный гриб, как и любой живой организм, подвержен заболеваниям и негативным воздействиям окружающей среды. Чаще всего виновниками его недугов становятся владельцы, которые не уделяют должного внимания уходу. Например, при замене питательной среды гриб может получить механические повреждения — порезы, надрывы или проколы.
Тем не менее, такие повреждения обычно не влияют на жизнедеятельность симбиотической колонии микроорганизмов, обладающих способностью к регенерации. Поэтому механические травмы можно считать условными заболеваниями чайного гриба. Если повреждения значительные, рекомендуется поместить гриб в небольшое количество питательного раствора, чтобы он слегка покрывал поврежденную область, до полного восстановления.
Плесень на чайном грибе
Плесень — еще одна проблема, влияющая на качество этого ценного продукта. Наиболее подвержены заражению молодые грибы, которые не успели развить необходимый уровень кислотности (pH) в напитке.
Плесень образуется только на поверхности гриба, контактирующей с воздухом. В таких случаях лучше всего удалить гриб.
Чаще всего плесень появляется из-за нарушения температурных условий, задымленности помещения от постоянного курения или хранения банки в шкафу.
Бурые пятна на грибе
Бурые пятна на поверхности гриба свидетельствуют о попадании заварки или нерастворённого сахара. В этом случае необходимо удалить повреждённый слой. В дальнейшем чайный раствор следует фильтровать через несколько слоёв марли или специальное сито. Сахар нужно тщательно размешать в чае до полного растворения, и только после этого питательную смесь можно заливать на тело гриба.
Появление зелёных водорослей
В случае нарушения технологического процесса в растворе чайного гриба могут появляться сине-зелёные водоросли. Они могут оседать на стенках банки или плавать в растворе, придавая ему мутный оттенок. Это происходит при снижении температуры ниже 18 °C, попадании прямых солнечных лучей на банку или высоком уровне pH (7,5–8,5) питательной среды. После тщательного промывания гриба и устранения нарушений размножение водорослей прекращается.
Мушки в летнее время
В теплое время года чайный гриб привлекает мушек-дрозофил. Эти насекомые attracted веществами, образующимися в результате ферментации сахара дрожжами. Мушки откладывают яйца в теле гриба, и их личинки начинают питаться продуктами его жизнедеятельности. Поэтому рекомендуется накрывать банку с настоем марлей и обклеивать края сосуда липкой лентой.
Гриб опускается на дно
После пересадки в новую ёмкость гриб обычно опускается на дно. Это естественная реакция на стресс, вызванный перемещением. Многие пользователи отмечают, что материнский гриб из купленных наборов часто оказывается на дне. Он поднимается на поверхность, как только формируется новая плёнка молодой комбучи. Если гриб не всплывает, его следует удалить.
Иногда комбуча оказывается на дне без видимых причин. В таком случае рекомендуется подождать 1-2 дня и попробовать подкормить гриб, а затем понаблюдать за его состоянием. Если в течение 10-12 дней гриб не поднимется, а при дегустации не ощущается газировка и характерная кислинка, это может означать, что ваш «питомец» погиб. Если же всё происходит нормально, поводов для беспокойства нет.
Гриб потемнел
Некоторые люди удивляются, когда замечают, что культурный гриб темнеет и теряет светло-белый цвет, как на фотографиях в интернете. Это естественный процесс. В чае содержатся красители, которые могут изменить окраску гриба. Например, черный чай придает ему коричневый оттенок.
Также изменение цвета может происходить из-за длительного нахождения гриба в одном растворе. Рекомендуется сливать настой, промывать гриб и заливать его свежезаваренным чаем.
Гриб почернел
Если гриб полностью почернел, его следует удалить. Это может свидетельствовать о наличии проблемы.
Гриб порвался
В этом нет ничего страшного: комбуча — самовосстанавливающаяся культура. Даже если вы случайно разрежете её на две части, это не повлияет на процесс ферментации. Просто дайте ей немного питания, и она восстановится самостоятельно за несколько дней.
Гриб расслоился
Это нормальное явление: каждые две недели образуется новый гриб, который отслаивается. Возможно, вы не заметили момент, когда «потомство» нужно было удалить вручную. Отслоившийся слой просто убирается.
Напиток пузырится
Пузыри — это скопления углекислого газа, которые свидетельствуют о том, что чайный напиток готов к употреблению.
Напиток не газируется
Это указывает на то, что гриб находится в неудовлетворительном состоянии, и процесс ферментации проходит менее активно, чем необходимо. Причины могут быть различными: низкая температура окружающей среды, повреждение гриба горячим чаем или нехватка сахара.
Чтобы восстановить здоровье гриба, его можно заново подкормить. Важно следить за температурой чая — она не должна превышать 30 °С. Если у вас нет готового напитка для закваски, используйте непастеризованную крафтовую комбучу. Наблюдайте за процессом в течение 10-15 дней и, если потребуется, повторите кормление. Если сладкий чай не стал кислым и на поверхности не образовались пузырьки, вероятно, гриб погиб.
Напиток стал кислым
Вероятно, процесс брожения затянулся. В следующий раз старайтесь не оставлять комбучу слишком долго. Также учитывайте, что высокая температура в месте хранения банки может ускорить закисление.
Если ваша комбуча оказалась слишком кислой, есть несколько способов это исправить. Во-первых, можно разбавить её сладким чаем или добавить напиток из другой партии комбучи. Во-вторых, перекисшую комбучу можно использовать в качестве закваски для следующей порции — это не повлияет на качество нового напитка.
В готовом перелитом напитке образуется мутный белый слой
Появление мутного белого налета в готовом напитке — это естественный процесс. Хотя основной медузомицет был удален, в напитке остаются живые дрожжи и бактерии, которые продолжают медленное брожение. Со временем это может привести к образованию нового гриба.
Как правильно пить чайный гриб?
Чайный гриб — отличное средство для борьбы с различными заболеваниями, подходящее как взрослым, так и детям. Регулярное употребление настоя из чайного гриба укрепляет иммунную систему, очищает организм и улучшает состояние кожи, волос и ногтей. Он также способствует снижению веса и нормализации обмена веществ. Этот ароматный и освежающий напиток помогает справиться с похмельем.
Рекомендуется пить настой из чайного гриба отдельно от еды. Лучше всего употреблять его не ранее чем через 2 часа после приема пищи или за 30 минут до трапезы. Напиток, выпитый натощак (от 1 до 1,5 стакана), подготовит пищеварительную систему к перевариванию пищи. Полстакана перед сном поможет расслабиться и настроиться на отдых. Оптимальная дневная норма составляет 1 стакан настоя.
Как сделать фруктовую комбучу?
Этапы вторичной ферментации фруктов:
- Для вторичной ферментации ягод и фруктов используйте сосуд с герметичной крышкой. Оптимально подойдет бутылка из темного стекла, но можно использовать и обычную банку с закручивающейся крышкой.
- Подготовьте ягоды или фрукты с желаемым вкусом (например, клубнику, облепиху, арбуз, лайм или ароматные травы). Их количество должно составлять примерно 1/5 объема сосуда (можно добавить до 1/4 для более насыщенного вкуса), чтобы они свободно помещались в бутылке.
- Поместите ягоды в бутылку и залейте их готовой комбучей.
- Оптимальная температура для ферментации — 25℃, а продолжительность — 1-2 дня.
- Рекомендуется проверять напиток через сутки. Откройте крышку: если выделяется много газа, напиток готов. Процедите его (или оставьте ягоды) и уберите в холодильник. Если газа недостаточно, оставьте на еще сутки.
- Ниже представлены 7 проверенных рецептов с комбучей.
Основные правила вторичной фруктовой ферментации:
- Для более яркого фруктового аромата ягоды и фрукты лучше измельчить в блендере. Их объем должен составлять 1/5 от объема сосуда.
- Среднее время ферментации — 2 дня под плотно закрытой крышкой. Если вы используете очень сладкие фрукты (или варенье с высоким содержанием сахара), срок сокращается до одного дня. Тепло (летом) также ускоряет процесс, возможно, вам хватит и суток. Некоторые овощи, например, имбирь, могут также ускорить ферментацию.
- Когда комбуча будет готова, при открывании крышки выделяется много газа (как после открытия газированного напитка), поэтому открывайте ее над раковиной.
- Чтобы избежать резкого выброса газа, открывайте каждую бутылку дважды в день — утром и вечером, чтобы предотвратить накопление давления. Учтите, что при хранении комбучи в холодильнике газы выделяются менее активно.
- Не рекомендуется ферментировать более трех дней без открытия крышки, так как это может привести к взрыву бутылки.
[Видео] Как ароматизировать чайный гриб различными ягодами и фруктами?
[Видео] 7 очень вкусных рецептов фруктовой комбучи:
7 проверенных рецептов фруктовой комбучи:
- Арбузный сок.
- Половинка лайма + столовая ложка мяты (сушеной или несколько веточек свежей).
- Вишня без косточек + пол чайной ложки корицы.
- Персик + чайная ложка чабреца.
- Две столовые ложки имбиря + две чайные ложки куркумы.
- Клубника + мята.
- Сушеные яблоки + пол чайной ложки корицы.
Лечение чайным грибом
С древних времён чайный гриб считался целебным средством от множества недугов. В недалёком прошлом его разводили почти в каждой советской семье. Сегодня о его полезных качествах знают не только любители народной медицины — современные клинические исследования подтвердили эти свойства.
Лечение ногтей чайным грибом
Существует заболевание, известное как онихокриптоз, которое проявляется врастанием ногтя в боковую область ногтевого валика. Чаще всего это происходит на большом пальце ноги. На начальных стадиях наблюдается воспаление мягких тканей, а на более поздних могут появляться гнойные выделения. Если не принять меры, может потребоваться хирургическое вмешательство.
При своевременном обращении к лечению природные средства, основанные на народных рецептах, могут быть эффективными. Одним из таких средств является чайный гриб, который используется в виде компрессов. Для этого нужно отделить часть гриба, обернуть ею поражённый палец, накрыть пищевой пленкой и надеть сначала обычный носок, а сверху — шерстяной. После трёх таких процедур вросший ноготь размягчается, и его можно удалить самостоятельно.
Для волос
Существует множество методов ухода за волосами с использованием чайного гриба. Продукты на его основе укрепляют волосы, делают их более густыми и ускоряют рост, а также помогают при различных заболеваниях кожи головы. При проблемах с выпадением волос рекомендуется втирать настой чайного гриба в кожу головы легкими массирующими движениями. Чтобы добиться яркого и насыщенного цвета, а также сделать волосы мягкими и блестящими, полезно ополаскивать их настоем гриба после мытья.
Для улучшения состояния волос изнутри настой чайного гриба можно употреблять ежедневно перед приемом пищи. Это укрепит волосы и положительно скажется на их росте. Если вы хотите избавиться от перхоти, выполните следующие шаги: разделите волосы на пряди и по линии пробора наносите на корни настой, используя кусочек марли. Через 30–40 минут промойте волосы. Рекомендуется проводить эту процедуру после каждого мытья головы.
Для укрепления волос можно также приготовить смесь из одной столовой ложки меда и одного стакана настоя гриба. Смесь следует слегка подогреть, не доводя до кипения, и тщательно перемешать. Маску нужно равномерно распределить по влажным волосам. Через 20–30 минут волосы можно ополоснуть настоем ромашки.
От ногтевого грибка
Грибковое поражение ногтей — хроническое заболевание, которое разрушает ногтевые пластины и может передаваться окружающим, особенно членам семьи. Эта болезнь открывает двери для других инфекций и может вызвать аллергические реакции, а также усугубить такие состояния, как бронхиальная астма, аллергический дерматит и экзема.
Важно не игнорировать грибок, так как его можно эффективно лечить с помощью чайного гриба. Для этого отделите тонкий слой гриба и на ночь прикрепите его к поражённому пальцу. Сверху оберните компресс целлофаном и наденьте несколько носков, чтобы избежать загрязнения постельного белья, так как из гриба может выделяться сок. Первоначально процедура может вызвать дискомфорт, но преодолев эту боль, можно навсегда избавиться от недуга.
Утром снимите компресс, промойте ногу в тёплой воде, удалите омертвевшие участки кожи и обработайте поражённую область зелёнкой или раствором марганцовки. Процедуру следует повторять через день до полного исчезновения симптомов. Обычно на это уходит до семи сеансов. После завершения курса лечения можно проводить профилактические процедуры. Новый ноготь будет расти медленно, но он будет здоровым и ровным.
При диабете
Чайный гриб обладает способностью снижать уровень сахара в крови, что делает его полезным при лечении сахарного диабета. Однако его применение не подходит для всех форм заболевания, поэтому рекомендуется предварительно проконсультироваться с врачом. Употребление одного стакана настоя чайного гриба в день, разделенного на 3-4 порции, может значительно улучшить общее состояние организма, активизировать внутренние ресурсы для борьбы с болезнью и способствовать постепенному снижению уровня сахара в крови.
Исследования показывают, что регулярное употребление чайного гриба помогает снизить уровень сахара у пациентов с диабетом 2 типа. Анализ крови участников эксперимента продемонстрировал снижение уровня глюкозы на 30%.
Людям с сахарным диабетом рекомендуется разбавлять напиток минеральной водой или травяным чаем. На два литра чая не следует добавлять более 60 г сахара (примерно 4 столовые ложки). В процессе своей жизнедеятельности комбуча эффективно перерабатывает сахар, не оставляя его в напитке.
При язве желудка
При повышенной кислотности и язвенной болезни желудка не рекомендуется употреблять чайный гриб. В редких случаях можно попробовать настой гриба с мёдом, приготовленный на основе черного чая. Мёд помогает снизить влияние кислоты и предотвращает обострения.
Чайный гриб для похудения
Чайный гриб — это уникальное средство для снижения веса, которое усиливает лечебные свойства в сочетании с другими методами. Для достижения положительных результатов важно придерживаться правильного и здорового питания. Рекомендуется употреблять шесть стаканов чайного гриба в день: по одному стакану за час до еды и один стакан через два часа после. Курс применения составляет три месяца, после чего следует сделать недельный перерыв.
Чтобы усилить эффект, можно готовить настой грибов на чаях, способствующих похудению. Особенно вкусным и полезным он получается на основе травяных чаев. Напитки на базе чайного гриба помогают нормализовать обмен веществ и улучшают работу сердечно-сосудистой и кроветворной систем. Это способствует избавлению от отеков и жировых отложений, делая человека более привлекательным и стройным.
Побочные эффекты и противопоказания
Не рекомендуется употреблять настой чайного гриба людям с инсулинозависимым сахарным диабетом (диабет I типа). Также стоит избегать больших порций или настоев, которые начали бродить.
Тем, кто страдает острыми заболеваниями внутренних органов или проходит курс медикаментозного лечения, обязательно следует проконсультироваться с врачом.
При приготовлении комбучи важно строго придерживаться установленных правил и использовать посуду из стекла, пластика или нержавеющей стали.
Противопоказания
Употребление чайного гриба не рекомендуется в следующих случаях:
- Алкоголизм.
- Гипогликемия — продукт может понизить уровень сахара в крови, что ухудшает состояние.
- Синдром раздражённого кишечника — чайный гриб содержит кофеин, который может усугубить болезненные ощущения и вызвать диарею.
- Ослабленный иммунитет — при снижении защитных функций организма патогенные грибки и бактерии могут представлять опасность.
Побочные эффекты
Исходя из результатов исследования свойств чайного гриба, составлен список возможных побочных эффектов, которые могут возникнуть при его регулярном употреблении:
- Лактоацидоз.
- Проблемы с желудком.
- Нарушение работы печени.
- Появление дрожжевых инфекций.
- Аллергические реакции.
- Желтуха.
- Тошнота и рвота.
Часто задаваемые вопросы
-
Как часто и в каком количестве можно употреблять чайный гриб?
Исследования показывают, что безопасная доза комбучи для взрослого человека составляет 1/2 стакана в день. Соблюдение этой рекомендации не вызывает негативных последствий.
-
Можно ли давать чайный гриб детям?
Педиатры рекомендуют давать комбучу детям не чаще одного раза в 7-14 дней. Превышение этой дозы может привести к неприятным симптомам, так как гриб содержит свинец.
-
Безопасен ли чайный гриб для беременных и кормящих женщин?
На данный момент не проводились исследования о влиянии чайного гриба на беременных и кормящих женщин. Большинство специалистов советуют избегать употребления этого напитка в период беременности и лактации из-за наличия даже минимального количества алкоголя. Кроме того, комбуча может содержать плесневые грибы, что представляет опасность для здоровья беременной женщины и её малыша.
-
Можно ли есть сам чайный гриб?
Употребление сырого чайного гриба может вызвать:
- Проблемы с пищеварением.
- Вздутие живота.
- Тошноту.
- Обострение хронических заболеваний.
При термической обработке гриб становится вязким, меняет цвет на серый и приобретает неприятный вкус.
-
Можно ли хранить чайный гриб в холодильнике?
Напиток, полученный из ёмкости с чайным грибом, можно хранить в холодильнике. Однако сам гриб помещать туда не следует, так как низкие температуры замедляют процессы брожения и ферментации.
-
Содержит ли чайный гриб алкоголь?
В напитке из чайного гриба содержание алкоголя крайне низкое — всего 0,5%. Согласно стандартам ГОСТ, в квасе допустимо содержание этанола до 1,2%, а в пиве — от 3 до 5,5%. Таким образом, уровень спирта в комбуче сопоставим с безалкогольным пивом.
-
Можно ли пить чайный гриб при гастрите, подагре и панкреатите?
Гастрит. При гастрите с пониженной секрецией рекомендуется пить напиток за пару часов до еды. Оптимальная доза — 1 стакан в день. Курс лечения может длиться месяц, после чего следует сделать перерыв. Если гастрит сопровождается повышенной секрецией, в напиток можно добавить немного мёда — 1 чайная ложка на 200 мл жидкости поможет нейтрализовать кислоту.
Подагра. Людям с подагрой не рекомендуется постоянное употребление комбучи из-за риска накопления молочной кислоты. Однако краткосрочный приём может быть допустим для снятия воспаления. Конкретные рекомендации должен дать лечащий врач, основываясь на анамнезе и результатах анализов.
Панкреатит. При этом заболевании запрещены все продукты и напитки, кроме чистой негазированной воды. Существует мнение, что чайный гриб может помочь уменьшить воспаление и улучшить обмен веществ при заболеваниях поджелудочной железы, но исследований на эту тему не проводилось. В любом случае, употребление комбучи должно быть строго ограниченным и краткосрочным.
Соколова Нина Владимировна
Остались вопросы? Задавайте их в комментариях ↓
Другие полезные продукты:
Рейши
Гриб весёлка
Чага
Пивные дрожжи
Грибы дождевики
Рисовый гриб
Молочный гриб (тибетский, кефирный)
Лиственничная губка
Корица
Куркума
Вопрос-ответ
Какой вред от чайного гриба?
Несмотря на множество полезных свойств чайного гриба, возможен и вред от его употребления. Описаны единичные случаи токсического поражения печени, серьезных нарушений обмена веществ (накопление в крови лактата, снижение содержания натрия).
Сколько заварки и сахара нужно для чайного гриба?
Его кладут в вымытую сухую банку. В отдельной посуде готовится чай (на 1 л воды берется 100 г заварки), в котором растворяется 30-60 г сахара. Нужно обязательно растворить все крупинки, чтобы они не попали на гриб и не повредили его. Чай остужается и переливается в банку с грибом.
Советы
СОВЕТ №1
Перед тем как начать выращивать чайный гриб, убедитесь, что у вас есть все необходимые ингредиенты и условия. Вам понадобится чистая стеклянная банка, чай (черный или зеленый), сахар и чистая вода. Также важно выбрать теплое место, защищенное от прямых солнечных лучей, чтобы гриб мог развиваться в комфортной среде.
СОВЕТ №2
Регулярно проверяйте состояние чайного гриба. Он должен иметь однородную текстуру и приятный запах. Если вы заметили неприятный запах или плесень, лучше избавиться от гриба и начать заново. Также следите за уровнем жидкости в банке — она должна полностью покрывать гриб.
СОВЕТ №3
Не забывайте о гигиене. Перед тем как работать с чайным грибом, обязательно мойте руки и используйте чистую посуду. Это поможет избежать загрязнения и сохранить здоровье вашего гриба. Также не используйте металлические предметы, так как они могут повредить гриб.
СОВЕТ №4
Пробуйте разные виды чая и уровни сахара, чтобы найти идеальный вкус для вашего напитка. Чайный гриб может иметь разные оттенки и ароматы в зависимости от используемых ингредиентов, поэтому экспериментируйте, чтобы создать свой уникальный рецепт.